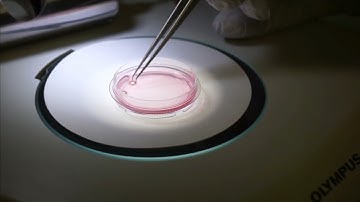

⬇ DOWNLOAD NOW
Kalau muncul iklan pop-up, tutup lalu klik tombol kembali
Download lagu HPM Live µ - routine use secara gratis hanya untuk keperluan promosi. Dukung artis favorit kamu dengan membeli musik original di iTunes atau platform resmi lainnya.
 HPM Live µ - routine use 20x
HPM Live µ - routine use 20x
Live Cell on the HPM Live µ
Live Cell on the HPM Live µ
 Schematic functioning of the CryoCapsule together with the High Pressure Freezer Live µ
Schematic functioning of the CryoCapsule together with the High Pressure Freezer Live µ
 Just A Routine Operation
Just A Routine Operation
 Begin met deze ochtendroutine na je 65e – Voeg tientallen jaren toe aan je leven! | Dr. Rhonda Pa...
Begin met deze ochtendroutine na je 65e – Voeg tientallen jaren toe aan je leven! | Dr. Rhonda Pa...
 Deze routine van 12 minuten draait je biologische leeftijd om
Deze routine van 12 minuten draait je biologische leeftijd om
 Are you ready to transform yourself?!💪🏻🚀# exercises#movement#routine#lesspain
Are you ready to transform yourself?!💪🏻🚀# exercises#movement#routine#lesspain
 Are you ready to transform yourself?!💪🏻🚀# exercises#movement#routine#lesspain
Are you ready to transform yourself?!💪🏻🚀# exercises#movement#routine#lesspain